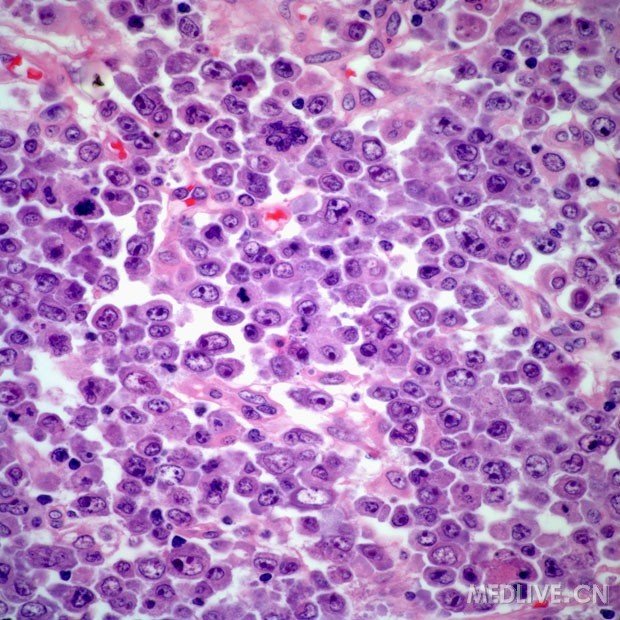
胃癌病理图片

胃腺癌病理切片

胃腺癌
图片尺寸1600x1200
胃癌病理图片
图片尺寸620x620
涨知识,早期胃癌病例诊治过程全分享!
图片尺寸809x537
胃癌病理图片
图片尺寸620x620
胃:腺癌?讨论病例【山东省消化道早癌病理群38】
图片尺寸4608x3456
胃:腺癌?讨论病例【山东省消化道早癌病理群38】
图片尺寸4608x3456
图20,21 管状腺癌病理示意图
图片尺寸955x775
图1 原发性胃腺癌来源:cancernetwork1 楼关注站内信thorns
图片尺寸620x620
胃:腺癌?讨论病例【山东省消化道早癌病理群38】
图片尺寸4608x3456
胃腺癌,光学显微镜
图片尺寸1200x800
胃腺癌
图片尺寸1600x1200
胃癌病理图片
图片尺寸620x620
女75岁 胃底贲门见巨大肿块 乳头状腺癌? - 消化系统 - 91360病理论坛
图片尺寸2540x1692
狡猾的肿瘤君1例早期胃癌现形记
图片尺寸373x280
胃底病变esd 管状腺癌讨论病例【山东省消化道早癌病理群】
图片尺寸3968x2976
胃腺癌,光学显微镜
图片尺寸1200x800
女75岁 胃底贲门见巨大肿块 乳头状腺癌? - 消化系统 - 91360病理论坛
图片尺寸2404x1670
胃窦体:腺癌?讨论病例【山东省消化道早癌病理群149】
图片尺寸4608x3456
胃体病变管状腺癌侵犯粘膜肌山东省消化道早癌病理群
图片尺寸4608x3456
胃底病变esd 管状腺癌讨论病例【山东省消化道早癌病理群】
图片尺寸3968x2976